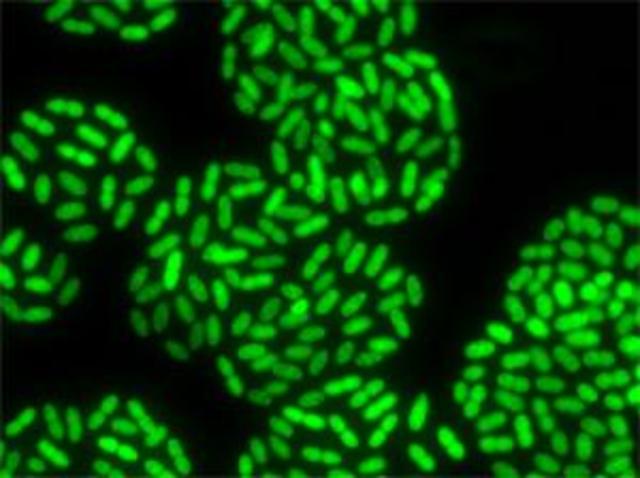
3.7 b y a

-
birthof the solar
-
earth began to form
-
Bacteria diversify.
-
photosynthesizing bacteria
-
oldest fossils
-
oxygen appears in the environment,causing damage to living tissues.
-
oldest eukaryote fossils
-
protective ozonelayerin place
-
major glaciation period beging.
-
lahd plants
-
Reptiles
-
oxygen nears present daylevels.
-
perrnian aopercent
-
crocodiles dinosaurs manmals.
-
pangaea starts to break apart.
-
cretaceous 60- 80 percent.
-
primates.
-
Hominids
-
modern hunans Late pleistocehe 45 pounds.
Plan projects on a visual timeline
Map milestones, phases, deadlines, and key events in one place so the sequence is easier to see and share. Timetoast is a timeline maker for work, school, research, and stories.